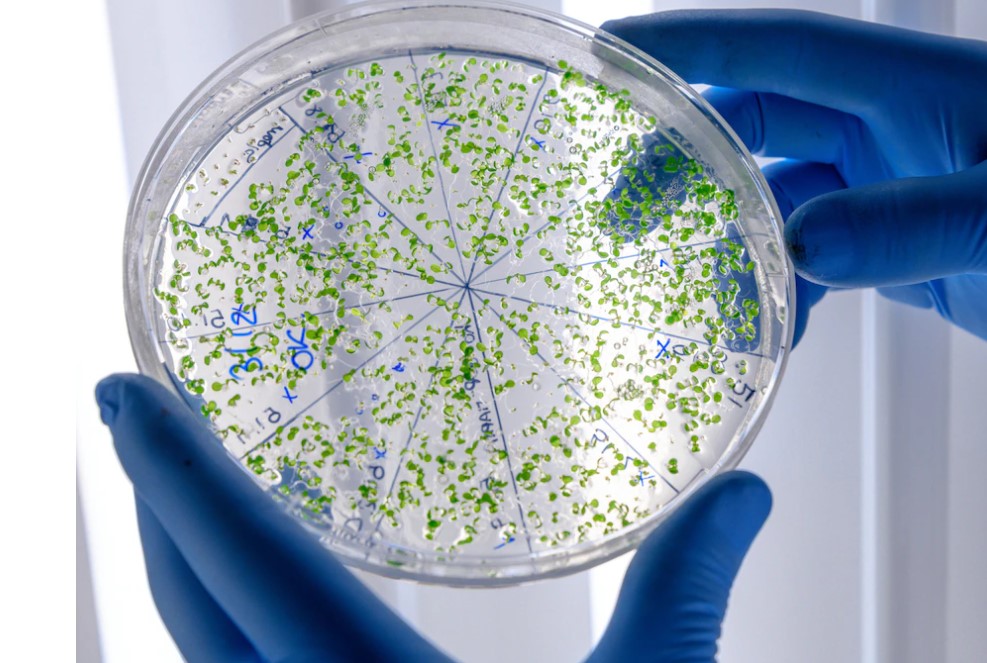

Стол справок
ПН - ПТ (07:00-20:00):
(8-017) 352-65-81
(8-017) 355-65-82
(8-025) 501- 30-85
(8-017) 300-48-33 (амб.)
Вызов врача на дом
ПН - ПТ (07:30-19:30); СБ (08:30-14:30):
(8-017) 377-64-94
(8-017) 369-88-46
Приемная главного врача:
(8-017) 374-21-01 (тел./факс)
Платные услуги (пн-пт: 08:00-20:00):
Бухгалтерия (08:30-17:00):
(8-017) 377-03-61 (тел./факс)
Отдел юридической и кадровой работы
(ПН-ЧТ: 08:30-17:00) (ПТ: 08:30-16:10):
(8-017) 316-65-17
Планово-экономический отдел
(08:30-17:00):
(8-017) 374-05-12